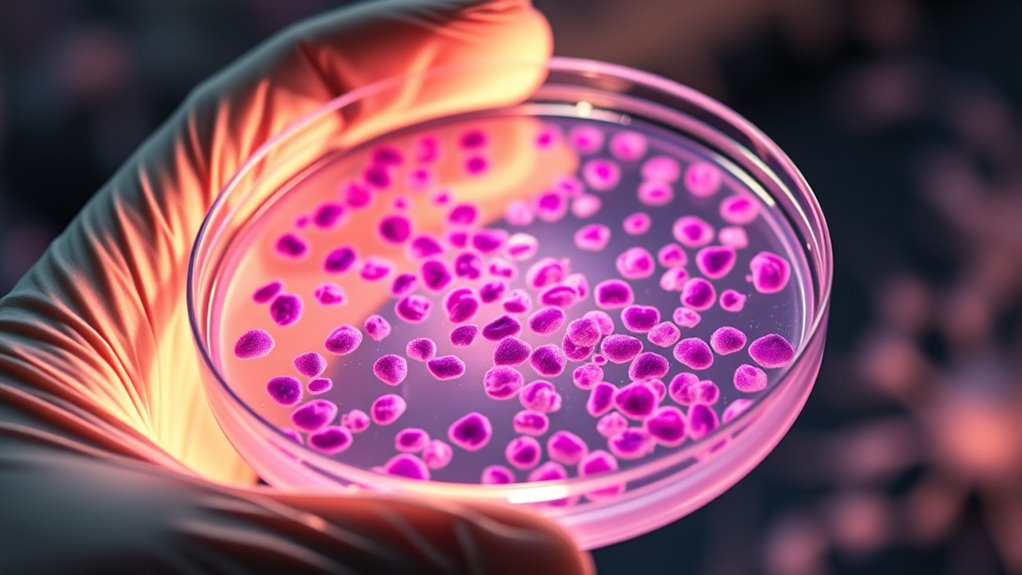
gezielte DNA-Reparaturhemmung

PARP-Inhibitoren sind zielgerichtete Therapien, die gezielt Brustkrebszellen mit BRCA-Mutationen angreifen, indem sie deren DNA-Reparaturprozess blockieren. Sie nutzen eine Schwäche namens synthetische Letalität, wodurch Krebszellen Schäden anhäufen und absterben, während gesundes Gewebe geschont wird. Obwohl sie wirksam sind, kann sich Widerstand entwickeln. Wenn Sie verstehen möchten, wie diese Behandlungen funktionieren, welche Herausforderungen bestehen und welche zukünftigen Fortschritte es gibt, gibt es im Folgenden mehr zu entdecken.
Wichtige Erkenntnisse
- PARP-Inhibitoren nutzen die synthetische Letalität, indem sie DNA-Reparaturdefekte bei BRCA-mutierten Brustkrebspatienten ausnutzen.
- Sie hemmen PARP-Enzyme, was zur Anhäufung von DNA-Schäden führt und selektiven Krebszellentod verursacht.
- Klinische Studien zeigen, dass PARP-Inhibitoren wie Olaparib die progressionsfreie Überlebenszeit bei BRCA-mutierten Brustkrebspatienten verbessern.
- Resistenzmechanismen umfassen sekundäre Mutationen, die die homologe Rekombination wiederherstellen, sowie eine erhöhte Medikamenten-Ausscheidung.
- Die Kombination von PARP-Inhibitoren mit Immuntherapien und biomarker-gesteuerten Ansätzen erhöht die Behandlungseffektivität.
Olaparib PARP inhibitor medication
As an affiliate, we earn on qualifying purchases.
As an affiliate, we earn on qualifying purchases.
Verstehen der Rolle von BRCA-Mutationen beim Brustkrebs

Haben Sie sich jemals gefragt, warum bestimmte Brustkrebsarten unterschiedlich auf Behandlungen ansprechen? Es hängt alles mit Genetik zusammen, insbesondere mit BRCA1- und BRCA2-Mutationen. Diese Gene sind essenziell für die Reparatur von DNA durch einen Prozess namens homologe Rekombination, der eine genaue Reparatur von Doppelstrangbrüchen sicherstellt. Wenn Sie eine Mutation in einem dieser Gene erben, haben Ihre Zellen Schwierigkeiten, DNA-Schäden richtig zu beheben. Dadurch werden die Krebszellen anfälliger für Behandlungen, die ihre Reparaturschwächen ausnutzen. Nur etwa 10-15 % der Brustkrebsarten tragen BRCA-Mutationen, doch ihre Präsenz macht diese Tumoren empfindlicher gegenüber bestimmten Therapien wie PARP-Inhibitoren. Das Verständnis dieser genetischen Unterschiede hilft, Behandlungspläne zu personalisieren und bietet Hoffnung auf bessere Ergebnisse bei Patientinnen mit BRCA-mutiertem Brustkrebs.
BRCA mutation genetic testing kit
As an affiliate, we earn on qualifying purchases.
As an affiliate, we earn on qualifying purchases.
Die Wissenschaft hinter PARP-Hemmung und synthetischer Letalität
Die Wirksamkeit von PARP-Inhibitoren bei BRCA-mutiertem Brustkrebs hängt von einem Konzept ab, das als synthetische Letalität bezeichnet wird. Dieses nutzt spezifische Schwachstellen in den DNA-Reparaturwegen von Krebszellen aus. Wenn man die PARP-Enzyme blockiert, verhindert man die Reparatur von Einzelstrangbrüchen (SSBs). Bei BRCA-mutierten Zellen, in denen homologe Rekombination (HR) defekt ist, führt dies zum Anstieg von Doppelstrangbrüchen (DSBs), die nicht richtig repariert werden können. Dies verursacht tödliche DNA-Schäden und zum Zellsterben. Wichtige Punkte sind:
- PARP-Inhibitoren blockieren PARP1 an Schadensstellen, wodurch die Reparatur behindert wird.
- Bei BRCA-mutierten Zellen ist die HR-Reparatur defekt, was sie von PARP abhängig macht.
- Die sich ansammelnden DSBs überfordern die Reparaturmechanismen und führen zum Zelltod.
- Normale Zellen tolerieren PARP-Hemmung aufgrund intakter HR-Reparaturwege.
Dieser gezielte Ansatz tötet Krebszellen selektiv, während gesunde Gewebe geschont werden.
breast cancer DNA repair test
As an affiliate, we earn on qualifying purchases.
As an affiliate, we earn on qualifying purchases.
Klinische Evidenz zur Unterstützung von PARP-Inhibitoren bei BRCA-mutierten Fällen

Klinische Studien haben gezeigt, dass PARP-Inhibitoren wie Olaparib und Talazoparib die progressionsfreie Überlebenszeit (PFS) bei Patienten mit BRCA-mutiertem metastasiertem Brustkrebs deutlich verbessern. Die OlympiAD-Studie zeigte eine mediane PFS von 7,0 Monaten mit Olaparib im Vergleich zu 4,2 Monaten mit Standard-Chemotherapie. Ebenso berichtete EMBRACA über eine mediane PFS von 8,6 Monaten für Talazoparib gegenüber 5,6 Monaten für Chemotherapie. Die folgende Tabelle fasst die wichtigsten Studienergebnisse zusammen:
| Studienname | Medikament | Mediane PFS | Ansprechrate |
|---|---|---|---|
| OlympiAD | Olaparib | 7,0 Monate | 59% |
| EMBRACA | Talazoparib | 8,6 Monate | 55% |
| Phase I | Olaparib | 47% Ansprechen | k.A. |
| Phase III | Talazoparib | Signifikanter PFS-Vorteil | k.A. |
Diese Ergebnisse bestätigen die Rolle der PARP-Inhibitoren als wirksame zielgerichtete Therapien bei BRCA-mutiertem Brustkrebs. Zusätzlich wird in laufenden Studien weiterhin erforscht, personalisierte Behandlungsansätze zu entwickeln, um die Ergebnisse für betroffene Patientinnen zu optimieren.
personalized cancer treatment guide
As an affiliate, we earn on qualifying purchases.
As an affiliate, we earn on qualifying purchases.
Wie PARP-Hemmer wirken, um den Tod von Krebszellen zu verursachen

PARP-Inhibitoren führen zum Tod von Krebszellen, indem sie die Reparatur von Einzelstrangbrüchen (SSBs) stören, die sich ansammeln, wenn PARP-Enzyme blockiert sind. Wenn PARP gehemmt wird, werden SSBs nicht richtig repariert, was zu ihrer Anhäufung führt. Während der DNA-Replikation verursachen diese unreparierten SSBs das Zusammenbrechen der Replikationsgabeln, was zu Doppelstrangbrüchen (DSBs) führt. Bei BRCA-mutierten Krebszellen können defekte homologe Rekombination (HR)-Reparaturen diese DSBs nicht reparieren, was zum Zelltod führt. Normale Zellen mit funktionierenden BRCA-Genen können DSBs effektiv reparieren. Dieses spezifische Schwachstellenmuster wird durch synthetische Letalität ausgenutzt, bei der Krebszellen mit HR-Defekten gezielt angegriffen werden. Durch das Festhalten von PARP an Schadensstellen verstärken die Inhibitoren DNA-Schäden, wodurch Krebszellen an den Rand ihrer Reparaturfähigkeit getrieben werden und sie absterben.
Herausforderungen: Widerstand gegen PARP-Inhibitoren und wie er sich entwickelt

Widerstand gegen PARP-Inhibitoren stellt eine bedeutende Hürde dar, um ihre therapeutischen Vorteile für BRCA-mutierte Brustkrebspatientinnen aufrechtzuerhalten. Man kann beobachten, dass Tumoren sekundäre Mutationen in BRCA1 oder BRCA2 entwickeln, die die homologe Rekombination wiederherstellen und die Zellen weniger abhängig von PARP-vermittelter Reparatur machen. Zusätzlich können Krebszellen die Expression von Medikamentenwirkstoff-Transportern wie MDR1 erhöhen, was die intrazellulären PARPi-Spiegel verringert. Verlust oder Mutation von PARP1 selbst kann die effektive Trapping verhindern und so zur Resistenz führen. Einige Tumoren schützen Replikationsgabeln durch alternative Wege, um die Genome-Stabilität trotz PARP-Hemmung aufrechtzuerhalten. Diese Mechanismen ermöglichen es Krebszellen, trotz Therapie zu überleben, was zum Therapieversagen führt. Das Verständnis, wie Widerstand entsteht, ist entscheidend für die Entwicklung von Strategien, um dem entgegenzuwirken und die langfristigen Ergebnisse für Patientinnen zu verbessern. Außerdem kann Farbgenauigkeit bei der Erkennung subtiler DNA-Schäden die Wirksamkeit von PARP-Inhibitoren und die Entwicklung von Resistenzen beeinflussen.
Strategien zur Überwindung von Widerstand und Verbesserung der Behandlungsergebnisse

Um die Behandlungsergebnisse bei BRCA-mutiertem Brustkrebs zu verbessern, erforschen Wissenschaftler verschiedene Strategien, um Resistenzen gegen PARP-Inhibitoren zu überwinden. Es ist möglich, PARPi mit anderen zielgerichteten Therapien zu kombinieren, um Widerstandsmechanismen zu umgehen. Der Einsatz von Biomarkern, um Patienten zu identifizieren, die wahrscheinlich ansprechen, kann die Behandlungspräzision verbessern. Die Entwicklung von zukunftsweisenden PARP-Inhibitoren, die PARP effektiver einfassen, könnte Resistenz verhindern. Darüber hinaus könnte die Zielgerichtetheit auf Proteine, die an Replikationsgabelschutz beteiligt sind, die Sensitivität wiederherstellen. Das Verständnis von Innenarchitektur Prinzipien kann ebenfalls bei der Entwicklung von Kombinationstherapien helfen, indem effektivere Liefer- und Unterstützungsumgebungen geschaffen werden.
Ausweitung der Nutzung von PARP-Hemmern über BRCA-Mutationen hinaus

Während BRCA-Mutationen weiterhin die primären Marker für die Sensitivität gegenüber PARP-Inhibitoren darstellen, zeigen neuere Erkenntnisse, dass deren Nutzen über diese genetischen Veränderungen hinausgeht. Tumoren mit anderen Defekten im homologen Rekombinationsweg oder hoher Replikationsstress könnten ebenfalls auf PARP-Hemmung ansprechen. Dies erweitert die Behandlungsmöglichkeiten für Patienten ohne BRCA-Mutationen und könnte einer breiteren Population zugutekommen. Forscher untersuchen Biomarker, um diese Kandidaten zu identifizieren, darunter genomische Narben, die auf einen HR-Defekt hinweisen. Einige Tumoren mit somatischen BRCA-Mutationen oder Mutationen in anderen HR-bezogenen Genen zeigen vielversprechende Reaktionen. Dieser Ansatz könnte PARPi von einer gezielten Therapie für BRCA-mutierte Krebserkrankungen zu einer inklusiveren Behandlungsstrategie wandeln und so die Ergebnisse für Patienten mit unterschiedlichen genetischen Hintergründen verbessern. Zudem könnte ein besseres Verständnis der DNA-Reparaturmechanismen zur Entwicklung von Kombinationstherapien führen, die die Wirksamkeit bei verschiedenen Tumortypen steigern.
Verwaltung von Nebenwirkungen und Optimierung der PARP-Inhibitor-Therapie

Die Nebenwirkungen zu managen und die PARP-Inhibitor-Therapie zu optimieren, sind entscheidende Schritte, um die Behandlungsvorteile zu maximieren und Risiken zu minimieren. Um dies effektiv zu tun, sollten Sie die Patienten engmaschig überwachen und Dosen individuell anpassen, um Toxizität zu verringern. Häufige Nebenwirkungen sind Müdigkeit, Übelkeit, Anämie und Haarausfall. Diese können Sie durch supportive Maßnahmen wie Antiemetika oder Bluttransfusionen bei Bedarf behandeln. Zusätzlich sollten Sie eine Dosisanpassung oder Pausen in Erwägung ziehen, wenn schwere Nebenwirkungen auftreten. Um die Therapie zu optimieren, ist es wichtig, die Patienten über frühe Symptommeldungen und Adhärenz aufzuklären. Denken Sie an diese wichtigen Punkte:
- Regelmäßige Blutuntersuchungen, um hämatologische Nebenwirkungen frühzeitig zu erkennen
- Unterstützende Medikamente gegen Übelkeit und Müdigkeit einsetzen
- Dosen anpassen oder Pausen einlegen, um die Toxizität zu verringern
- Patienten über Nebenwirkungen und deren Management aufklären
- Verifizierte Sicherheitsmaßnahmen integrieren, um die Risiken der Therapie weiter zu reduzieren
Zukünftige Richtungen und aufkommende Forschung im Bereich PARP-zielgerichteter Behandlungen

Forscher konzentrieren sich auf die Überwindung von Resistenz gegen PARP-Inhibitoren, indem sie alternative Reparaturwege ins Visier nehmen und Next-Generation-Medikamente entwickeln. Die Kombination von PARPi mit Immuntherapie zeigt vielversprechende Ansätze zur Verstärkung der Anti-Tumor-Reaktionen, aber Sicherheit und Wirksamkeit müssen sorgfältig geprüft werden. Zudem zielt die Erweiterung der Biomarker-Strategien darauf ab, mehr Patienten zu identifizieren, die von PARP-gezielten Behandlungen profitieren können, auch außerhalb der BRCA-Mutationen. Darüber hinaus kann das Verständnis der Gesetz der Anziehung-Prinzipien Forschern helfen, eine positive Einstellung zu bewahren und innovative Ansätze in diesem sich entwickelnden Feld zu fördern.
Überwindung von Resistenzmechanismen
Das Überwinden des Widerstands gegen PARP-Inhibitoren ist ein entscheidendes Forschungsgebiet, da er die langfristige Wirksamkeit dieser Therapien bei BRCA-mutiertem Brustkrebs einschränkt. Widerstandsmechanismen umfassen sekundäre Mutationen, die die homologe Rekombination (HR) reparatur wiederherstellen, erhöhte Medikamenten-Ausscheidung durch MDR1-Transporter, Verlust oder Mutation von PARP1, die eine effektive Trapping verhindern, sowie eine Reduktion des PARP-Trappings durch PARG-Verlust. Zudem können Krebszellen den Schutz der Replikationsgabeln durch die Aktivierung alternativer Wege aufrechterhalten, was die Genomstabilität trotz PARPi bewahrt. Um diese Herausforderungen anzugehen, erforschen Wissenschaftler Kombinations-Therapien mit Wirkstoffen, die diese Widerstandswege gezielt angreifen, entwickeln Next-Generation-PARP-Inhibitoren, die weniger anfällig für Resistenzen sind, und identifizieren Biomarker, um die Reaktion vorherzusagen. Diese Strategien sollen die Wirksamkeit von PARPi verlängern und die Behandlungsoptionen für resistente Tumoren erweitern. Die Integration von Top-Matratzenauflagen und anderen Komfortsteigerungen kann zudem dazu beitragen, die Therapietreue der Patienten zu verbessern und das gesamte Behandlungserlebnis zu optimieren.
Kombination von PARPI mit Immuntherapie
Die Kombination von PARP-Inhibitoren mit Immuntherapie bietet einen vielversprechenden Ansatz, um die Behandlungseffektivität bei BRCA-mutiertem Brustkrebs zu erhöhen. Diese Strategie nutzt die potenzielle Synergie zwischen DNA-Schäden und Immunsystemaktivierung. PARPi induzieren den Zelltod der Tumorzellen und erhöhen die Freisetzung von Neoantigenen, die das Immunsystem stimulieren können. Wenn sie mit Immunscheckpoint-Inhibitoren wie PD-1- oder PD-L1-Blockern kombiniert werden, kann die Immunantwort weiter verstärkt werden, was möglicherweise die Immunflucht überwindet. Früh klinische Studien zeigen vielversprechende Anzeichen für verbesserte Ansprechraten und progressionsfreie Überlebenszeiten bei dieser Kombination. Allerdings bleiben die Optimierung der Dosierung, das Management von Nebenwirkungen und das Verständnis, welche Patienten am meisten profitieren, Herausforderungen. Die laufende Forschung zielt darauf ab, diese Kombinationen zu verfeinern, Biomarker für die Reaktion zu untersuchen und neue Standards für die Integration von Immuntherapie in PARP-Inhibitor-Regimen bei BRCA-mutiertem Brustkrebs zu etablieren. Zusätzlich untersuchen laufende Studien Mechanismen der Immunaktivierung, um besser zu verstehen, wie die therapeutischen Vorteile maximiert werden können.
Erweiterung der Biomarker-Strategien
Da die Verwendung von PARP-Inhibitoren über BRCA-mutierte Tumoren hinaus ausgeweitet wird, wird die Identifizierung zuverlässiger Biomarker zur Vorhersage des Behandlungserfolgs immer wichtiger. Es ist notwendig, über BRCA-Mutationen hinauszublicken, um die Patientenauswahl und -ergebnisse zu verbessern. Neue Strategien konzentrieren sich auf die Erkennung von homologer Rekombinationsdefizienz (HRD), genomischen Narben oder Mutationen in anderen Reparaturgenen. Diese bieten eine umfassendere Sicht auf die Schwachstellen des Tumors. Außerdem sollten funktionelle Tests in Betracht gezogen werden, die die DNA-Reparaturfähigkeit direkt messen. Zusätzlich kann die Untersuchung der Tumormutationslast (TMB) und immunologischer Signaturen Hinweise auf die Reaktionsfähigkeit auf Kombinationstherapien geben. Durch Verfeinerung dieser Biomarker können Sie Behandlungen personalisierter gestalten und Resistenzen überwinden. Der Schlüssel liegt darin, genetische, funktionelle und molekulare Daten zu integrieren, um die Vorteile der PARP-Therapie für vielfältige Patientengruppen zu erweitern. Umfassende Biomarker-Analyse kann die Vorhersage der Behandlungseffektivität zusätzlich verbessern.
Häufig gestellte Fragen
Können PARP-Inhibitoren bei Tumoren ohne BRCA-Mutation, aber mit homologer Rekombinationsdefizienz, wirksam sein?
Ja, PARP-Hemmer können auch bei nicht-BRCA-homologer Rekombinationsdefizienz-Tumoren wirksam sein. Wenn Ihr Tumor andere Defekte in DNA-Reparaturwegen aufweist, wie Mutationen in anderen HR-bezogenen Genen oder erhöhte Replikationsstress, können PARP-Hemmer durch synthetische Letalität dennoch funktionieren. Forscher untersuchen aktiv diese erweiterten Anwendungsbereiche, um Biomarker zu identifizieren, die die Reaktion vorhersagen, über BRCA-Mutationen hinaus, und so die Vorteile der PARP-Hemmer möglicherweise erweitern.
Was sind die langfristigen Nebenwirkungen der PARP-Inhibitor-Therapie?
Sie sollten sich bewusst sein, dass eine langfristige PARP-Inhibitor-Therapie zu Nebenwirkungen wie anhaltender Blutbildveränderungen führen kann, was Ihr Risiko für Infektionen, Anämie und Blutungen erhöht. Während sich einige Nebenwirkungen nach Absetzen der Behandlung verbessern können, könnten andere, wie Müdigkeit oder potenzielle Zweitkanken, bestehen bleiben oder sich im Laufe der Zeit entwickeln. Eine enge Überwachung Ihrer Gesundheit und das Gespräch mit Ihrem Arzt über alle anhaltenden Symptome helfen, diese langfristigen Risiken effektiv zu managen.
Wie können wir vorhersagen, welche Patienten eine Resistenz gegen PARP-Inhibitoren entwickeln werden?
Sie können die Resistenz gegenüber PARP-Inhibitoren vorhersagen, indem Sie auf sekundäre BRCA1/2-Mutationen überwachen, die die homologe Rekonstruktion (HR) reparatur wiederherstellen, wodurch die Krebszellen weniger anfällig werden. Zusätzlich kann eine erhöhte Expression von MDR1-Transportern den Wirkstoff aus der Zelle pumpen, was seine Wirksamkeit verringert. Der Verlust oder die Mutation von PARP1 selbst oder Veränderungen in Proteinen, die die Replikationsgabeln schützen, deuten ebenfalls auf eine potenzielle Resistenz hin. Regelmäßige genetische Tests und Biomarker-Analysen helfen, diese Mechanismen frühzeitig zu erkennen.
Gibt es Biomarker außer BRCA-Mutationen, um geeignete PARPI-Kandidaten zu identifizieren?
Sie könnten denken, dass BRCA-Mutationen die einzigen zuverlässigen Biomarker sind, aber wenn Sie Ihren Blick erweitern, ergeben sich weitere Optionen. Homologe Rekombinationsdefizienz (HRD)-Wertungen, genomische Narben und Mutationen in Genen wie PALB2 oder ATM können auf PARPi-Sensitivität hinweisen. Diese Biomarker helfen dabei, Patienten jenseits von BRCA-Mutationen zu identifizieren, was eine persönlichere und effektivere Behandlungsstrategie ermöglicht—besonders wichtig, wenn Widerstandsmechanismen auftreten und die Möglichkeiten für zielgerichtete Therapien sich erweitern.
Welche Kombinationstherapien sind vielversprechend, um die Wirksamkeit von PARP-Inhibitoren zu verbessern?
Sie sollten in Betracht ziehen, PARP-Inhibitoren mit Immun-Checkpoint-Inhibitoren zu kombinieren, da dieser Ansatz die Immunantwort gegen Tumoren verstärken könnte. Zusätzlich zeigt die Kombination von PARPi mit Wirkstoffen, die auf DNA-Damage-Response-Wege abzielen, wie ATR- oder WEE1-Inhibitoren, vielversprechende Ergebnisse, um Resistenzmechanismen zu überwinden. Die Kombination von PARPi mit antiangiogenen Medikamenten oder Chemotherapie wird ebenfalls untersucht, allerdings bleibt die Bewältigung sich überschneidender Toxizitäten eine Herausforderung bei diesen Strategien.
Schlussfolgerung
Stellen Sie sich Ihre Krebszellen als eine Festung unter Belagerung vor, bei der PARP-Hemmer wie geschickte Infiltratoren agieren, die Schwachstellen in BRCA-mutierten Tumoren ausnutzen. Über 30 % der BRCA-bezogenen Brustkrebsarten sprechen gut auf diese zielgerichteten Therapien an, sodass Sie eine mächtige Waffe einsetzen. Mit fortschreitender Forschung werden Sie neue Strategien entdecken, um Resistenzen zu überwinden und die Behandlungsmöglichkeiten zu erweitern, um die Wende zu Ihren Gunsten zu gestalten und Hoffnung auf wirksamere, personalisierte Behandlungen zu bieten.









